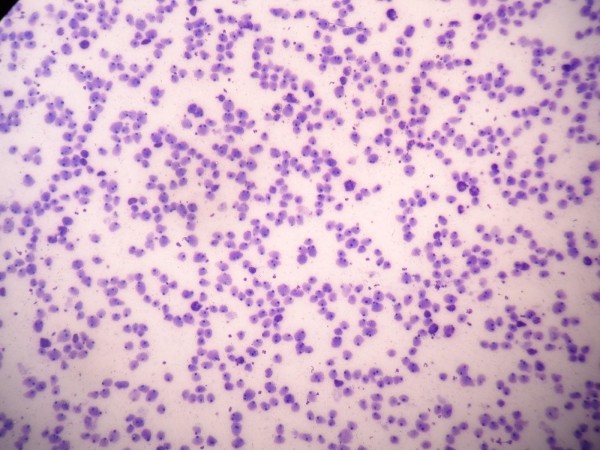
Image

FeLV-positive cat life expectancy addresses one of the most pressing concerns cat owners face after a diagnosis of FeLV. Feline Leukemia Virus remains a serious viral condition that affects immune function and overall health stability. When guardians understand how FeLV influences cat life expectancy, they can make informed and responsible decisions about daily care and veterinary support. Although FeLV can shorten lifespan in some cases, early testing and structured management significantly improve outcomes. Clear information, consistent monitoring, and realistic expectations help families support cats living with FeLV with confidence and compassion.
Understanding FeLV and How It Develops
FeLV stands for Feline Leukemia Virus, a contagious retrovirus that affects cats worldwide. The virus spreads primarily through saliva during grooming, shared bowls, or close contact, though it can also transmit through bites and from mother to kitten. Once inside the body, the virus integrates into the cat’s DNA and interferes with normal cell function. Some cats eliminate the virus during early exposure, while others develop persistent infection. Persistent infection places strain on the immune system and increases vulnerability to secondary illness.
The virus does not cause illness in the same way for every cat. Some cats remain stable for months or years without major symptoms. Others develop complications related to anemia, lymphoma, or chronic infections. The variation explains why cat life expectancy with FeLV differs widely. Veterinary evaluation helps determine whether infection is progressive or regressive, which shapes long-term planning.
How FeLV Affects the Immune System

FeLV weakens the immune response by targeting white blood cells and bone marrow. When immune cells function poorly, the body struggles to fight bacteria, viruses, and parasites. Minor infections that would normally resolve quickly may become persistent or severe. This immune suppression explains why immune support for cats with FeLV becomes a cornerstone of care.
Bone marrow suppression can also reduce red blood cell production. Some cats develop anemia, which leads to fatigue, pale gums, and decreased appetite. Monitoring blood values allows veterinarians to intervene before complications escalate. Regular blood tests serve as an early warning system that guides treatment adjustments.
Cat Life Expectancy with FeLV
Cat life expectancy following an FeLV diagnosis depends on several measurable factors. Age at diagnosis, viral load, overall health status, and environmental conditions all influence survival. Some studies indicate that persistently infected cats may live an average of two to three years after diagnosis, though many exceed this range with attentive management. Regressively infected cats can live near normal lifespans if their immune systems control viral replication.
It is important to frame expectations realistically. FeLV remains a serious condition that can lead to life-limiting complications. However, prognosis improves when cats receive routine veterinary monitoring, stable nutrition, and stress reduction. Early diagnosis through screening tests significantly influences long-term outcome because it allows intervention before advanced disease develops.
Stages and Prognosis
Veterinarians classify FeLV infections based on how the virus behaves in the body. Abortive infection occurs when the immune system eliminates the virus before it establishes itself. Regressive infection involves viral integration without persistent viremia, meaning the virus remains dormant with minimal active replication. Progressive infection results in continuous viral replication and a higher risk of complications.
Prognosis correlates strongly with these stages. Cats with regressive infections often maintain stronger immune defenses and stable blood values. Cats with progressive infection require closer monitoring because they face greater risk of anemia, lymphoma, and recurrent infections. Diagnostic testing over time helps clarify which pattern applies to each individual cat.
Why Early Testing Matters
Early testing protects both the infected cat and other cats in the household. A simple blood test identifies FeLV status and allows owners to adjust housing arrangements promptly. Kittens and newly adopted cats benefit from screening before introduction to resident pets. Early detection also reduces stress because it replaces uncertainty with actionable information.
When testing occurs before symptoms appear, veterinarians can establish a monitoring plan immediately. Baseline blood work provides a reference point for future comparison. Subtle changes in red or white blood cell counts can signal the need for supportive therapy. Timely action often slows progression and improves cat life expectancy.
Supportive Treatments and Feline Leukemia Virus Management
There is no cure that eliminates FeLV from the body once persistent infection develops. Management focuses on maintaining immune stability and preventing secondary illness. Supportive treatments may include antiviral medications in select cases, immune modulators, and prompt treatment of bacterial infections. Pain management and appetite support become essential if complications arise.
Routine veterinary visits every six months help detect emerging problems early. Blood panels, weight checks, and dental assessments reduce preventable stressors on the immune system. Many guardians also seek educational resources such as the Pet Life 2026 feline wellness education platform when learning about long-term feline wellness and daily health routines. Reliable education empowers owners to recognize warning signs quickly and respond appropriately.

The Importance of an Indoor Lifestyle
Indoor housing significantly influences life expectancy in FeLV-positive cats. Outdoor exposure increases the risk of trauma, additional infections, and viral spread to other cats. An indoor environment reduces stress and allows closer observation of appetite, litter habits, and behavior. Controlled surroundings act like a protective barrier that shields a compromised immune system from unnecessary challenges.
Environmental enrichment remains essential even within indoor settings. Climbing structures, window perches, and interactive play maintain muscle tone and mental engagement. Mental stimulation supports overall health by reducing chronic stress hormones that can suppress immunity further. Safe indoor living offers both physical protection and emotional stability.
Nutrition and Immune Support for Cats
Nutrition forms the foundation of Feline Leukemia Virus management. High-quality, balanced diets support tissue repair and immune cell production. Wet food often helps maintain hydration and kidney health, particularly if anemia develops. Protein quality matters more than volume because immune cells rely on amino acids for function.
Raw diets remain controversial for immunocompromised cats because bacterial contamination poses additional risk. Most veterinarians recommend commercially prepared, nutritionally complete diets that meet established safety standards. Supplements should only be introduced under veterinary guidance because evidence for many immune boosters remains limited. Measured, evidence-based decisions protect long-term stability.
Vaccination and Prevention Strategies
Preventing FeLV in uninfected cats remains one of the most effective strategies for controlling the disease. Vaccination protects at-risk cats who live with infected companions or who may encounter unknown cats. Testing before vaccination ensures that already infected cats do not receive unnecessary immunization. Responsible breeding and adoption screening reduce transmission within communities.
Education plays a crucial role in prevention. Owners who understand transmission pathways can limit sharing of bowls and litter trays between infected and uninfected cats. Routine veterinary advice tailored to household risk level provides practical safeguards. Prevention reduces the emotional and financial burden associated with chronic viral management.
Veterinary Monitoring and Lifespan Extension
Consistent veterinary monitoring extends lifespan by identifying subtle changes early. Weight loss, dental disease, or mild anemia can progress silently without regular exams. Semiannual blood work helps detect declining immune function before a clinical crisis occurs. Early intervention frequently prevents hospitalization and supports a stable quality of life.
Monitoring also includes behavioral observation at home. Changes in grooming habits, activity levels, or appetite often signal underlying stress or illness. When owners report these shifts promptly, veterinarians can adjust care plans quickly. Proactive partnership between guardian and clinician remains one of the strongest protective factors for FeLV-positive cats.
Living Well with FeLV
An FeLV diagnosis carries emotional weight, yet many cats continue to enjoy meaningful years with attentive care. Stability comes from routine, cleanliness, and predictable feeding schedules. Guardians who organize medication times and veterinary appointments reduce chaos that can stress a vulnerable immune system. Calm environments, gentle handling, and consistent affection reinforce psychological well-being.
Realistic optimism benefits both owner and cat. While FeLV can shorten cat life expectancy in progressive cases, careful Feline Leukemia Virus management improves comfort and longevity for many individuals. Early testing, indoor protection, balanced nutrition, and veterinary partnership create a framework for responsible care. With structured support and informed decision-making, FeLV-positive cats can live lives defined not solely by diagnosis but by the quality of care they receive.





